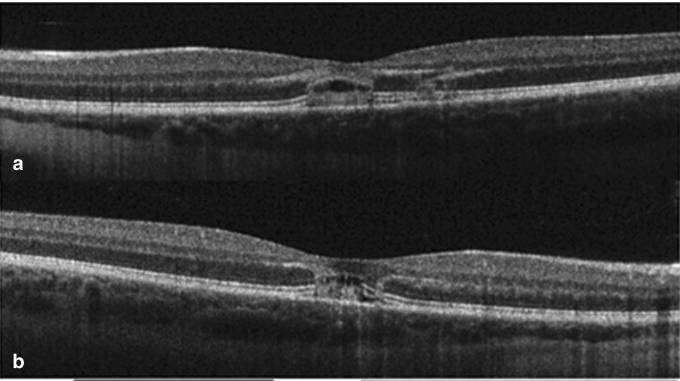
Bild

Bitte halten Sie Laserpointer von Kindern fern.
Im Internet kann man problemlos Hochleistungslaserpointer kaufen, doch in den Händen von Kindern wird es gefährlich!
Was passiert, wenn ein Laserpointer ins Auge strahlt? Die Augenoberfläche bleibt möglicherweise unversehrt. Aber bedeutet das, dass alles in Ordnung ist?
Nein, der Laser trifft direkt auf die Netzhaut, und zwar oft auf die wichtigste Stelle – die Makula – und hinterlässt dort eine Art "Loch".
Kann sich das Sehvermögen wieder erholen? Wie lange dauert es? Gibt es Folgeschäden?
Das sind die dringendsten Fragen der Eltern.
Werfen wir einen Blick auf einige Fälle, um die Antworten zu finden.
FALL 1
Ein 9-jähriger Junge erlitt eine Laserpointer-Verletzung der Makula im linken Auge. Die bestkorrigierte Sehschärfe sank auf 0,4.

In der Makula zeigt sich eine gelbliche Läsion, die OCT-Aufnahme offenbart das "Loch" wie unten dargestellt:
Nach 2 Monaten erholte sich die Sehschärfe auf 0,67, nach 19 Monaten schließlich auf 1,0. Allerdings war die Makulaempfindlichkeit des linken Auges herabgesetzt, und das "Loch" blieb bestehen.
FALL 2
Ein 11-jähriger Junge erlitt Laserpointer-Verletzungen beider Augen. Die Sehschärfe sank auf 0,8.
Nach 8 Wochen sank die Sehschärfe des rechten Auges auf 0,5 und die des linken Auges auf 0,4. Der Augenhintergrund zeigte folgende Befunde, mit Diskontinuitäten in der ellipsoiden Zone der Photorezeptoren und der äußeren Grenzmembran.
Nach 12 Monaten erholte sich die Sehschärfe beider Augen auf 0,67. Dennoch blieb die Makulaempfindlichkeit beider Augen herabgesetzt, und die "Löcher" in der Makula waren weiterhin sichtbar.
Anhand dieser Fälle können wir einige Erkenntnisse gewinnen und die Fragen der Eltern beantworten.
Kann sich das Sehvermögen erholen? Wie lange dauert es?
Es kann sich teilweise erholen. Im schlechtesten der oben genannten Fälle betrug die Sehschärfe nach einem Jahr 0,67.
Zusätzlich bleibt oft eine herabgesetzte Makulaempfindlichkeit bestehen.
Gibt es Folgeschäden?
Ja! Es verbleiben "Löcher" in der Makula, und regelmäßige Nachuntersuchungen sind notwendig...